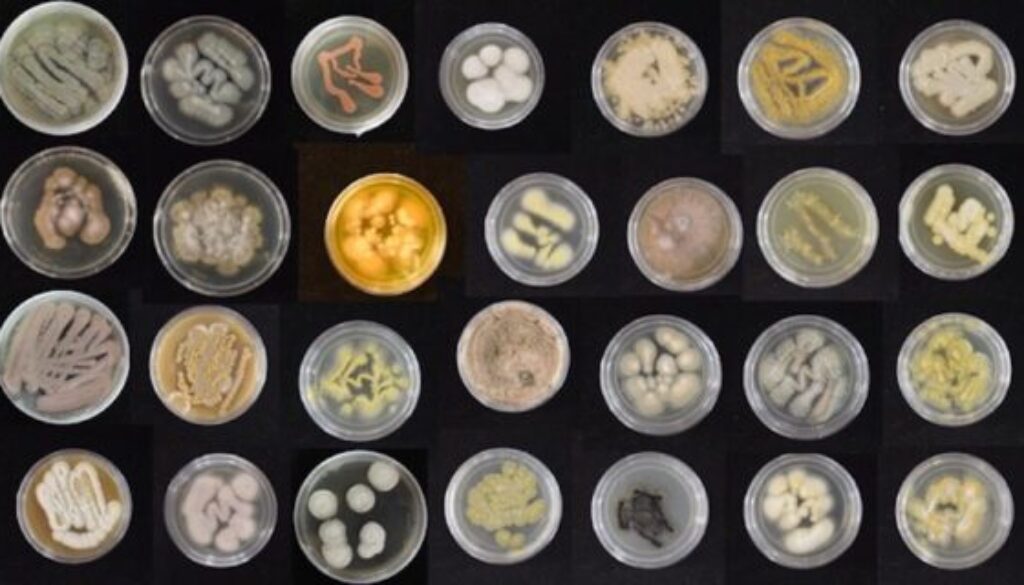
IMG_0815_variety-of-marine-fungi-_-Syrena-Whitner-copy-569x320

Mighty marine fungi degrade plastic, can train to do it faster
Source: https://www.soest.hawaii.edu/soestwp/announce/news/mighty-fungi-degrade-plastic/
Plastic is the most prevalent marine pollutant and plastic surfaces are the fastest growing habitat in the ocean. Researchers at the University of Hawai‘i at Mānoa recently discovered that many species of fungi isolated from Hawai‘i’s nearshore environment have the ability to degrade plastic and some can be conditioned to do it faster.
“Plastic in the environment today is extremely long-lived, and is nearly impossible to degrade using existing technologies,” said Ronja Steinbach, who led this research as a marine biology undergraduate student in the UH Mānoa College of Natural Sciences. “Our research highlights marine fungi as a promising and largely untapped group to investigate for new ways to recycle and remove plastic from nature. Very few people study fungi in the ocean, and we estimated that fewer than one percent of marine fungi are currently described.”
For consumers, plastics are cheap, strong, and useful, but plastic waste is problematic because rather than decomposing, it breaks into microplastics when exposed to sunlight, heat, and physical force. Plastics are harmful to marine ecosystems—they can concentrate dangerous chemicals, such as phthalates and bisphenol A; entrap or harm animals; or be ingested and lead to starvation in marine animals due to malnutrition. With the equivalent of about 625,000 garbage trucks of plastic entering the ocean each year, finding ways to degrade these compounds is critical.
Microbes with superpowers
Various microbes, including bacteria and terrestrial fungi, have been tested for their ability to degrade plastics with the hope that biotechnology can, one day, be deployed at ecologically relevant scales. While many terrestrial fungi have previously been found to degrade various types of plastic, the team of researchers from the UH Mānoa School of Ocean and Earth Science and Technology (SOEST) focused their attention on their large collection of fungi they isolated from sand, seaweed, corals, and sponges in Hawai’i’s nearshore.
“Fungi possess a superpower for eating things that other organisms can’t digest (like wood, or chitin), so we tested the fungi in our collection for their ability to digest plastic,” said Anthony Amend, Pacific Biosciences Research Center professor, who leads the lab where Steinbach and Syrena Whitner, study co-author marine biology graduate student, conducted the research.
To do this, the team filled small dishes with polyurethane, a common plastic, often used in medical and industrial products such as foams, flexible materials, and adhesives, and measured whether and how fast the fungi consumed plastic. The researchers took the fungi that grew the fastest and experimentally evolved them to see if, over time with greater exposure to the polyurethane, these fungi could adapt to eat plastic faster and more efficiently.
“We were shocked to find that more than 60% of the fungi we collected from the ocean had some ability to eat plastic and transform it into fungi,” said Steinbach. “We were also impressed to see how quickly fungi were able to adapt. It was very exciting to see that in just three months, a relatively short amount of time, some of the fungi were able to increase their feeding rates by as much as 15%.”
Because of Hawai‘i’s location in the North Pacific Subtropical Gyre, ocean currents deliver to our shores plastic waste from around the world, and nearby is the Great Pacific Garbage Patch.
The UH Mānoa team is now expanding on their research to see if these promising fungi, and others, can eat different types of plastic, like polyethylene and polyethylene terephthalate, that are even harder to degrade, and even larger sources of marine pollution. The scientists are also trying to understand, at a cell and molecular level, how fungi are able to degrade these compounds.
“We hope to collaborate with engineers, chemists, and oceanographers who can leverage these findings into actual solutions to clean up our beaches and oceans,” shared Steinbach.